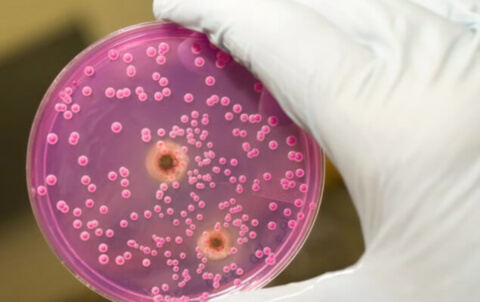

Полностью избавиться от грибковых микроорганизмов невозможно. Однако изменение образа жизни и правильная тактика лечения, подобранная врачом, поможет остановить их рост и уменьшит их количество до нормы. В этой статье вы узнаете всё про кандидоз, его симптомы и лечение.
Отчего возникает болезнь
В небольшом количестве дрожжеподобные грибки рода Кандида присутствуют в организме любого человека. Однако при возникновении иммунодефицита начинается их активный рост, защитные силы организмы не справляются, и возникает болезнь.
Также существуют негативные факторы, которые способны спровоцировать заболевание. Их разделяют на 2 большие группы:
Благодаря им, инфекция проникает в организм через поврежденную кожу (ожоги, порезы, трещины). Например, поражение слизистой оболочки рта может возникнуть из-за плохой гигиены, пародонтита, неправильно подобранных протезов.
К ним относятся заболевания, которые приводят к снижению иммунитета, а также врожденное состояние иммунодефицита. Это авитаминоз, гормональные сбои, нарушения обмена веществ, анемия, хронические патологии ЖКТ, сахарный диабет.
Признаки кандидоза могут появиться из-за частого воздействия на кожу или слизистые оболочки химических веществ. Привести к болезни также могут прием гормональных контрацептивов, злоупотребление алкоголем, курение, неблагоприятная экология в месте проживания и частые стрессы.
Как проявляется кандидоз
Проявления этого инфекционного заболевания разнообразны. Они зависят места возникновения и от того, какой орган был атакован дрожжеподобными грибками рода Сandida. Рассмотрим основные виды болезни и ее симптомы.
Развивается на поверхности кожи и ее придатков (волосы, ногти), а также поражает слизистые оболочки губ, ротовой полости, половых органов и анальную область.
- Кандидоз ротовой полости и гортани
Чаще всего жалобы заключаются в том, что человека беспокоит жжение, сухость или дискомфорт во рту. Боль становится сильнее во время приема пищи. Слизистая оболочка полости рта становится отечной, появляются небольшие высыпания белого цвета. Может образоваться беловатая пленка или сильный серый налет.
- Поражения кожи, ногтей и волос
При кожном кандидозе – симптомы на начальной стадии проявляются в виде слегка заметной белой полоски в складках кожи. Затем присоединяется зуд, и возникают эрозийные поражения. Мелкие пузырьки сливаются, и грибковое заболевание распространяется на здоровые участки. Если в результате расчесывания присоединится вторичная инфекция, то возникают язвы.
Когда грибковая инфекция поражает ногти, сначала возникает покраснение ногтевого валика, а затем возможно появление гнойников. Сама ногтевая пластина становится хрупкой, может трескаться, возникает пульсирующая боль.
Кандидозное поражение волосяных фолликулов встречается не часто. Проявляется такое заболевание образованием гнойной сыпи в месте роста волос на голове или в области бороды, усов.
- Кандидоз половых органов
У женщин во влагалище условно-патогенные микроорганизмы рода кандида присутствуют постоянно, и в норме никак себя не проявляют. Но под воздействием неблагоприятных факторов их количество увеличивается, и тогда у женщины возникает кандидоз или молочница.
Обычно жжение и зуд в области половых мужских органов ощущается спустя 2-3 часа после контакта. Однако через пару дней симптомы ослабевают или полностью проходят до следующей половой связи. В тяжелых случаях возникают множественные гнойники, которые с половых органов могут перейти на кожу (паховые складки).
Женская форма кандидоза сопровождается зудом, который усиливается во время движения, при половом акте и в период менструации. Возможны ощущения жжения, боли и дискомфорта. Часто возникают жалобы на густые, творожистые выделения. Внешне можно заметить отечную слизистую оболочку половых губ с небольшими точечными вкраплениями.
Эта форма заболевания характеризуется множественным поражением кожи, слизистых оболочек и внутренних органов. Она внешне проявляется в образовании плотного белого налета, после удаления которого образуются эрозии. Достаточно редкая форма заболевания, поэтому точные причины ее появления мало изучены. Проявляется общим недомоганием, вялостью, головными болями, апатией, повышением температуры.
Грибковые микроорганизмы инфицируют только внутренние органы и системы.
При поражении пищевода, желудка или кишечника появляется болезненные ощущения при глотании, чувство жжения, тошнота, рвота, частая отрыжка. Из-за боли во время приема пищи у человека падает аппетит, снижается вес, что влечет ухудшение общего самочувствия.
- Органы дыхания и воздухоносные пути
Грибковые микроорганизмы в гортань, трахею или бронхи могут попадать из пораженной полости рта. Характеризуется кашлем, затрудненным дыханием, зудом. Болезнь негативно влияет на голосовые связки, что может привести к хрипоте или временному исчезновению голоса.
Частой причиной поражения мочеполовых органов кандидозом является внутрибольничная инфекция. Также возможно появление такого заболевания в виде осложнения после операций. В основном протекает в форме таких болезней, как цистит, уретрит и пиелонефрит со всеми сопутствующими симптомами.
Если своевременно не начать адекватное лечение, то кандидозная инфекция любого вида приобретает хроническое течение.
Диагностические методы
Известно, что существует более 70 видов дрожжеподобных грибков рода Кандида. Многие их них способны привести к болезненным симптомам, поэтому предварительное обследование крайне важно для определения верного и действенного лечения.
Для определения возбудителя инфекционного заболевания обязательно проводится ряд лабораторных исследований. Диагностика кандидоза включает следующие методы:
- изучение биологического материала (кожи, слизи, налета). Для этого назначается кожный соскоб, мазки, а также берутся для изучения чешуйки, корки или налет со слизистых оболочек;
- гемотест на определения уровня глобулинов. Если их количество превышает норму, то значит, велика вероятность наличия инфекции;
- общие анализы: кал, моча, кровь. Необходимы при подозрении на системную форму кандидоза.
При поражении ЖКТ грибковыми микроорганизмами проводят эндоскопическое исследование. Часто оно назначается для забора материала для последующего детального лабораторного изучения. Также врач может назначить колоноскопию, бронхоскопию или рентген.
Тщательное предварительное исследование позволяет выявить вид грибка, а также его чувствительность к определенным бактериальным препаратам. Если этого не сделать, то лечение будет неэффективным, а болезнь усугубится. Ни в коем случае нельзя заниматься самолечением.
Врач подбирает медикаменты в зависимости от того, какой вид грибковой инфекции был выявлен. Для устранения внешних проявлений используются различные противогрибковые мази, гели, кремы. Проводится лечение сопутствующих заболеваний, особенно важно привести в порядок кишечную микрофлору.
Одновременно проводится иммуностимулирующая терапия. Это прием витаминов, изменение образа жизни, соблюдение рекомендованной диеты. Исключаются все мучные изделия, сахар, алкоголь и жирные продукты. Дополнить лекарственную терапию можно и народными средствами, но только после консультации с лечащим врачом.
Профилактические рекомендации
Любую болезнь легче предотвратить, чем лечить. Наличие условно патогенных микроорганизмов рода Кандида само по себе не представляет вреда для организма. Люди, у которых нет иммунодефицита, даже при постоянном контакте с возбудителем не заболевают кандидозом, так как иммунитет прекрасно справляется с инфекцией. Поэтому основной профилактикой является поддержание защитных сил организма в работоспособном активном состоянии. Для этого необходимо правильно питаться, заниматься физическими упражнениями, не запускать хронические заболевания, проходить профилактические осмотры.
Важным пунктом является питание. Многие продукты представляют собой питательную среду для активного роста дрожжеподобного грибка. Самым опасным в этом плане является сахар. Не злоупотребляйте сладостями и выпечкой.
Также исключите вредные привычки, старайтесь избегать стрессов, и позволяйте себе больше отдыхать на свежем воздухе. Антибиотики принимайте исключительно по рекомендации врача и только совместно с пробиотиками.
Обязательно соблюдайте личную гигиену. Особенно следует быть внимательными в общественных местах, где влажно и тепло. Это сауна, бассейн, баня.
Забота о себе – это основа крепкого здоровья, и тогда никакие инфекции не смогут нанести вред и привести к заболеванию. Но если вы заподозрили у себя симптомы грибковой инфекции, своевременно обращайтесь к врачу, и тогда вы сможете быстро справиться с недугом.
Кандидоз-заболевание, вызванное грибками, поражающее слизистую и кожу. Выделяют кандидоз мочеполовой системы, дыхательной и пищеварительной системы. Заболевание вызывают дрожжеподобные грибки семейства Кандида.
Причины появления кандидоза
Причин, способных вызвать кандидоз, насчитывается множество.
Среди основных можно выделить:
• Изменения в гормональном фоне.
• Заболевания, передающиеся половых путем.
• Хронические заболевания — онкология, сахарный диабет, туберкулез, ВИЧ-инфекция.
• Бесконтрольный прием лекарственных средств.
Грибок живет в каждом организме, но при благоприятных факторах, он начинает активно размножаться.
Классификация кандидоза
Классифицировать молочницу можно по степени распространенности и по степени развития инфекции. Различают:
• Поверхностная форма. Одна из самых легких форм проявления заболевания. Грибок находится только на поверхности кожи, ногтей и слизистых.
• Системная форма. При ней одновременно с поверхностными оболочками, грибок распространяется еще и на внутренние органы. Такая форма характерна для онкологических больных и ВИЧ-инфицированных, то есть у тех, у кого значительно снижены защитные силы организма.
• Острая. Имеет быстрое легкое течение. При адекватном и своевременном лечении излечивается в течение двух месяцев.
• Хроническая. При самолечении, отсутствии лечения и применения неэффективных средств кандидоз острой формы течения переходит в хроническую. Симптомы стерты. В большинстве случаев наблюдается у женщин.
• Персистирующая. Вялотекущая форма течения заболевания. Лечится сложно, то появляется, то исчезает.
• Рецидивирующая. Характеризуется систематическими вспышками. Обычно может появляться при сильных стрессах или после месячных.
• Кандидоносительство. Человек не имеет симптомов молочницы, но для окружающих он заразен.
• Врожденный вид кандидоза — мать во время беременности инфицирует ребенка.
• Кандидозный сепсис. Это очень опасная форма кандидоза. Грибок обнаруживается даже в крови. Возможны летальные исходы, так как тяжело лечить данную форму.
По месту скопления грибка кандидоз можно разделить на следующие виды:
• Молочница ротовой полости. Чаще всего наблюдается у грудных детей. Отмечается налетом на внутренней стороне щек, языке, губах. Может затрагивать небо и миндалины. Также появление такого вида молочницы возможно после орального секса с зараженным партнером.
• Кандидоз кожи и ногтей.
• Урогенитальная молочница. У женщин чаще всего проявляется гинекологическими заболеваниями — вагинитом и вульвитом. У мужчин может поразить поверхность полового члена, проявится циститом или поражением грибами мочеиспускательного канала.
• Кандидоз внутренних органов.
Симптоматика и признаки кандидоза
Для кандидоза ротовой полости характерно наличие небольших мест покраснений, отечность десен, языка, щек. Затем появляется творожистый налет. При этом виде кандидоза температура не повышается, нет увеличения лимфатических узлов. При наличии хронического кандидозного стоматита у больного отмечаются плотный, грубый налет. При снятии его появляются эрозии. Язык увеличивается и покрывается бороздками.
Кандидоз ротовой полости может поражать только уголки губ. В данном случае обязательно наличие трещинок или эрозий грязно-белого цвета с четкими формами и границами. При молочнице губ отмечается шелушение губ пластинками серого цвета, а также характерен синий цвет губ. Кандидоз на языке проявляется в виде кровоточащих язвочек, а затем появлением белого налета на них. С течением времени поражение распространяется и занимает большую поверхность.
В большинстве случаев при кандидозе внутренних органов поражается желудочно-кишечный тракт, бронхолегочная система, мочевыводящая система почки и половые органы. В целом это заболевание может затронуть любой орган и любую систему человека. Кандидоз дыхательной системы встречается редко.
Чаще всего он проявляется на фоне других тяжелых состояний и заболеваний. Например, бронхит и пневмония. При сопутствующем воспалительном процессе лечение кандидозного бронхита усложняется, и становиться длительным.
Это происходит из-за применения антибиотиков для лечения воспалений, а те, в свою очередь, наоборот, провоцируют развитие кандидоза. Симптомы похожи на симптомы туберкулеза. Появляется осиплость голоса, кашель. В процесс вовлекается глотка и гортань. Возможно повышение температуры.
Кандидоз желудочно-кишечной системы может протекать в двух формах — инвазивной и неинвазивной. При инвазивной форме течения заболевания на слизистой появляются язвы, симптоматика тяжелая. Неинвазивная форма отличается незначительным поражением слизистой.
Для кандидоза ЖКТ характерно:
• Тошнота и рвота. В выделяемых жидкостях заметны белые пленки.
• Понос. В содержимом также присутствуют белые пленки.
• Боль в желудке, кишечнике.
Кандидоз почек и других органов мочевыводящей системы редко является единичным заболеванием. Очень часто он наблюдается у больных с хроническим пиелонефритом. В моче содержится большое количество эритроцитов, почечный эпителий, а также белок.
При кандидозе головного мозга наблюдается тошнота, рвота и сильные головные боли.
Кандидозный вульвовагинит проявляется зудом, жжением, сильным или умеренным воспалением слизистой влагалища. Затем появляются следующие симптомы:
• Белые, творожистые выделения.
• Сухость половых губ, поверхность их немного белесая.
• Зуд, усиливающийся при мочеиспускании, после полового акта.
Урогенитальный кандидоз у мужчин:
• Баланит. Поражается поверхность полового члена. Наблюдается отечность, покраснение и язвочки. Относится к заболеваниям, передающихся половым путем. Может иметь осложнения.
• Урогенитальный кандидоз — поражает мочеиспускательный канал. Симптомы схожи с признаками гонореи.
• Цистит — поражение стенок мочевого пузыря. Характерно учащенное мочеиспускание, тяжесть в мочевом пузыре. Моча становится мутной, может наблюдаться кровь.
Диагностика урогенитального кандидоза
Анализ ставится на основе жалоб больного и результатов лабораторных исследований отделяемого влагалища и полового члена:
• Цитология и мазок на флору. В основном при этих анализах грибок виден хорошо, и дальнейшее исследование не нужно.
• Бак посев. Используется нечасто, потому что еще на фазе исследований на флору грибок обнаруживается. Посев дает возможность не только увидеть грибок, но и определить стадию заболевания.
Более сложные методы исследований при диагностике не используются.
Лечение молочницы половых органов
Для лечения кандидоза на половых органах используют препараты местного и общего назначения. Зависит лечение от степени тяжести и характера развития заболевания. При неосложненных формах бывает достаточным применение местных противогрибковых лекарственных средств. А в запущенных, хронических формах необходимо более длительный процесс лечения, в том числе и препаратами общего назначения.
Местная терапия проводится противогрибковыми препаратами в виде таблеток, свечей, мазей. Они содержат в себе нистатин, миконазол, пимафуцин, кетоконазол. Эти вещества хорошо зарекомендовали себя при лечении молочницы.
Также рекомендовано применение витаминов группы В и поливитаминов, для поднятия защитных сил организма.
Лечение проводится одновременно с двумя партнерами.
Профилактика кандидоза
• Соблюдение мер личной гигиены. Элементарная гигиена и частая смена прокладок и тампонов во время месячных значительно снижает риск развития молочницы. Запрещено пользоваться чужими средствами гигиены, мочалками и полотенцами.
• Половая гигиена — незащищенный половой акт или бурная сексуальная жизнь с разными партнерами ведет к заболеванию.
• Профилактические осмотры у врача.
• Избегать ношения синтетического белья, а также трусиков вида стринги. Ограничение ношения колготок в теплое время года.
• Правильное и рациональное питание. Сладкое, мучное и пряности способствуют развитию дрожжеподобного грибка. Рекомендовано употребление молочнокислой продукции, овощей и фруктов. Стоит отказаться и от жестких диет.
• Диагностика и лечение различных половых инфекций.
• Женщинам лучше отказаться от частых спринцеваний, так как вымываются лактобактерии, населяющие влагалище, меняется кислотность. Это моментально дает возможность развиваться грибку.
• Отказ от алкоголя, курения и наркотиков.
Главное, при симптомах кандидоза сразу же обратиться к врачу и начать лечение.
Молочница очень неприятное заболевание. Но соблюдение профилактических мер, правильное питание и здоровые привычки помогут забыть об этой неприятной болезни.
Многие женщины сталкивались с неприятной болезнью — молочницей. Это заболевание вызывает особый вид грибковой инфекции – кандидоз. Что такое грибок кандида, всегда ли он опасен, этот микроорганизм, который у здорового человека выполняет определенные функции, но при неконтролируемом распространении становится причиной болезней.
Candida albicans: описание
Что такое кандида? Грибок кандида – это одноклеточные организмы, которые широко распространены в природном мире. Грибки Кандида имеют более 100 разновидностей, но большинство из них не имеют отношения к развитию болезней у человека. Кандид — это что, враг или помощник оранизма?
Некоторые грибы рода Кандида могут поражать человеческий организм и вызывать тяжелые болезни, сопровождающиеся болью, жжением и зудом. Исследования показывают, что у 57% носителей инфекции грибки рода кандида находится на слизистых ротовой полости. Течение и проявление болезни зависит от того, к кому типу относятся грибки кандида, а также состояния иммунной системы пациента и наличия других хронических заболеваний.
Что такое кандиды? Это микроорганизмы, которые в здоровом женском организме вместе с лактобактериями и микроорганизмами создают правильную микрофлору. Но при нарушении здорового баланса грибковая культура начинает неконтролируемо разрастаться, вызывая заболевание.
Грибок рода candida могут выживать в разной среде, отличаются стойкостью к неблагоприятным воздействиям, поэтому иногда лечение грибка кандида бывает сложным.
Лучшая среда для развития грибков: отсутствие солнечного света, температура 21-37 градусов, высокая влажность. Именно поэтому грибки быстро размножаются в человеческом теле:
- во рту;
- на половых органах;
- в мочеиспускательном канале;
- на внутренних органах;
- в кишечнике.
Активность грибковой инфекции вызывает заболевание молочница – по-научному кандидоз. Болезнь может проявляться разными симптомами, нередко носитель молочницы даже не знает о наличии заболевания.
Важно! Заболевание развивается при отсутствии сдерживания роста микроорганизмов со стороны организма, то есть при переохлаждении, снижении иммунитета, нарушении рациона, стрессе и других ситуациях.
Виды молочницы
Кандида — это молочница, но только если грибковая популяция превышает норму. Разные виды кандиды провоцируют различные формы молочницы. Как правильно называется кандидоз в зависимости от степени тяжести или локации? Специалисты разработали даже условную классификацию видов грибковой инфекции, которая помогает выяснить причины болезни и разновидность кандиды. Молочница может иметь разные формы и виды.
- Поверхностная. Наиболее простой и легко поддающийся лечению кандидоз, грибок поражает кожу, ногти и слизистые оболочки. Эту болезнь также называются красная или махровая молочница.
- Системная. В этом случае грибок Кандида проникает в эпителий, поражая внутренние органы. Возможны нарушения функций дыхательной и пищеварительной системы. Этот вид болезни чаще встречается при наличии тяжелых хронических заболеваний, вызывающих ослабление иммунного ответа. Также системная молочница встречается у пациентов со СПИДом или онкологическими болезнями.
- Сепсис. В этом случае грибковый кандидоз поражает все системы организма, распространяясь через кровоток. В этом случае лечение очень сложное. Сепсис – это научное название заражения крови. От кандидоза наступает крайне редко, в запущенных случаях возможен летальный исход.
Обратите внимание! Без лечения поверхностный кандидоз может перейти в более тяжелые формы, вызывая системные поражения организма! Лечение кандидоза требует участия специалиста и соблюдения всех предписаний врача!
- Острая форма. Первая стадия, поддающаяся успешному лечению при верной диагностике и установления причин возникновения болезни. Симптомы заболевания проявляются за 2 месяца после заражения.
- Хроническая форма. Возникает при нарушении правил лечения или его отсутствии, а также при нечувствительности грибковой культуры к назначенным медикаментам. Хроническая форма подразумевает два вида грибка: либо вялый – персистирующий, либо систематичный — рецидивирующий.
- Кандидоносительная форма. В этом случае у пациента нет признаков болезни или дискомфорта, при этом анализы выявляют наличие в организме культуры грибка Кандиды. Пациент является распространителем грибковой инфекции, а заболевание проявится в активной форме при снижении иммунитета. Поэтому данная форма также требует лечения.
Специалисты разделяют молочницу не только по виду бактерий и форме заболеваний, но и области поражения – это необходимо для выяснения причин болезни и назначения грамотного лечения.
Важно! Молочница ослабляет организм, поэтому кожу или слизистые может поразить бактериальный или вирусный недуг. Поэтому лечение необходимо начинать быстро.
Симптомы заболевания
Молочница – что это такое? Это заболевание, которое вызывает кандида грибок. Молочница, медицинское название которой – кандидоз, могут поразить как детей, так и взрослого человека. Болезнь не имеет корреляции с возрастом или социальным положением пациента. Действительно, незащищенный секс с малознакомыми партнерами может стать причиной заражения молочницей, однако это единственная причина развития заболевания. Кроме того, молочница – это не венерическое заболевание, хотя она может свидетельствовать о наличии ЗППП.
Симптомы кандидоза разных локаций:
- Белый налет на языке, деснах или щеках;
- Белесые выделения из носа;
- Покраснение и болезненность пораженных зон;
- Творожистые выделения из влагалища;
- Появление кисловатого запаха от пораженного участка;
- Появление трещин на зараженной зоне;
- Зуд, жжение;
- Болезненность сексуального контакта;
- Повышенное либидо.
Обратите внимание! Зуд и жжение половых органов могут вызывать бактерии, а не грибок. Молочница ослабляет защитные функции организма, из-за чего патогенная бактерия может вызвать сопутствующее заболевание кожи или слизистой оболочки.
Что вызывает кандидоз?
Причины, вызывающие кандидоз, могут быть разными: от состояния здоровья до неблагоприятных воздействий окружающей среды. Однако есть факторы, которые чаще становятся причиной кандидоза.
- Прием антибиотиков. Лекарственные препараты этой группы способны нарушать естественный баланс микрофлоры. Если обнаружились признаки кандидоза, то лечение антибиотиками отменять не нужно, однако стоит ввести противогрибковые средства.
- Противозачаточные препараты. Средства, увеличивающие уровень эстрогена, способы стимулировать рост культуры кандиды и становится причиной молочницы.
- Психологическое напряжение. Молочница может быть проявлением стресса, депрессивного состояния, нервного срыва и других психологических перегрузок.
- Нарушение диеты. Обилие выпечки, сладостей, дрожжевого текста в рационе способно вызывать молочницу. Грибок кандида нуждается в глюкозе, и при ее получении начинает активно размножаться.
- Пиво. В составе хмельного напитка есть мальтоза, которая относится к сахарам и также является пищей для грибковой инфекции.
- Диабет. Повышенный сахар в крови также создает благоприятные условия для развития грибковой культуру и появлению молочницы.
- Нарушение правил гигиены. Редкий прием душа, использование некачественных прокладок или тампонов, ношение синтетического нижнего белья провоцируют рост грибковой популяции.
- Болезни ЖКТ. Нарушения работы ЖКТ, включая гастриты или частые запоры, становится причиной снижения иммунитета, из-за чего грибковая инфекция получает благоприятные условия для развития
Обратите внимание! Кандидоз может поразить несколько частей тела, поэтому для лечения требуется комплексный подход, включающий прием медикаментов внутрь и местного назначения.
Как лечить кандидоз? Необходимо пройти полное обследование у гастроэнтеролога, уролога, гинеколога, сдать анализы на ЗППП. Только после этого врач может назначить адекватное лечение с учетом причин, вызвавших заболевание.
При ответе на вопрос, чем лечить кандидоз у женщин и мужчин, не обходится без назначения противогрибковых препаратов. Патогенные грибы рода Candida успешно поддаются консервативному лечению, главное – не запускать течение патологического процесса. Адекватно подобранная терапия – это половина успеха на пути к скорому выздоровлению. Поэтому, чтобы вылечить грибок Кандида в организме, не стоит заниматься поверхностным самолечением, требуется своевременно обратиться к узкопрофильному специалисту за консультацией и диагностикой.
Что такое кандидоз
Это инфекционное заболевание, которое поражает слизистые мужского и женского организма при патогенных возбудителях Candida Albican. В медицинской практике можно столкнуться с кандидозом кишечника, половых органов, ротовой полости, причем во всех случаях можно заразиться от инфицированного человека. Местный иммунитет патологически снижен, поэтому среди комплексных терапевтических мероприятий в обязательном порядке должна присутствовать витаминотерапия. Если своевременно не лечить характерный недуг, заболевания мочеполовой сферы становятся хроническими.
Лечение
Если на слизистых оболочках преобладают споры грибов Candida Albican, основная цель предстоящего курса лечения – истребить патогенную флору, избавиться от неприятных симптомов кандидоза, восстановить травмированные ткани. Обязательно использование противогрибковых препаратов и лечебная диета с целью исключить благоприятные условия для развития, размножения вредоносных грибков. В зависимости от локализации очага патологии общие рекомендации специалистов таковы:
- При кандидозе половых органов патологический процесс сопровождается воспалением, зудом, жжением, присутствием вагинальных выделений. Чтобы избавиться от творожистых налетов со слизистой оболочки, необходимо использовать противогрибковые мази вагинально, дополнительно использовать местные антисептики.
- От кандидоза пищевода эффективно помогают противогрибковые средства для приема перорально, которые важно дополнить лечебной диетой с легкими, обезжиренными продуктами питания. Обязательно принимать витамины.
- При появлении очагов инфекции Candida Albican в полости рта, симптомы молочницы можно продуктивно устранить местными антисептиками. Интенсивная терапия антибиотиками назначается в осложненных клинических картинах. Дополнительная рекомендация – перед употреблением желательно охлаждать пищу.
Лечение кандидоза у мужчин
Если головку полового члена обнесло белым налетом творожистой консистенции, чаще заражение происходит от женщины. Эффективное лечение грибковых заболеваний у мужчин является наружное применение противогрибковых препаратов, укрепление иммунитета, использование антисептиков для обработки видимых очагов патологии. Вот какие рекомендации своим пациентам дают грамотные урологи при урогенитальных кандидозах:
- уместно местное использование кремов, мазей на основе Клотримазола: Канестен, Кандибене, Канизон, Антифунгол;
- домашние методы должны включать ванночки, где для приготовления лечебных составов рекомендуется использовать ромашку, календулу, тысячелистник;
- обрабатывать поверхность головки полового члена требуется содовым раствором, при этом важно избегать местного раздражения.
В результате отсутствия лечения, болезнь становится хронической, сложно поддается эффективному лечению. Чтобы не доводить до осложнений, при кандидозе обязательно использовать противогрибковые препараты в форме таблеток, мазей, растворов и гелей. Покупку совершать желательно по рецепту врача, при этом акцент требуется сделать на следующих фармакологических позициях:
- Канизон. Крем для использования наружно. Согласно инструкции, наносить состав требуется тонким слоем на поверхность головки и крайнюю плоть полового члена дважды за сутки на протяжении 5 – 7 дней.
- Канестен. Это еще одна производная Клотримазола в форме крема или спрея с выраженными бактерицидными, антимикотическими свойствами. Способ применения – аналогично вышеописанному медикаменту.
Медицинские препараты от кандидоза у мужчин предусматривают использование мазей наружно, чтобы убрать очевидные признаки молочницы в виде мелкой сыпи, отечности, покраснения головки, крайней плоти. Эффективное консервативное лечение Кандиды обеспечено при участии следующих медикаментов:
- Кетоконазол. Утром и вечером мазь требуется наносить на поврежденные участки тонким слоем, захватывая здоровые ткани. Лечить кандидоз предстоит на протяжении недели.
- Миконазол. Чтобы лечить кандидоз, требуется наносить на чистую кожу 2 раза за день на протяжении 14 дней без перерыва.
Лечение молочницы во рту у взрослых
Молочница ротовой полости чаще появляется у ребенка, однако взрослые подвержены такому заболеванию. Важно не только истребить инфекцию, но и восстановить травмированную слизистую оболочку ротовой полости. Для этого используют местные антисептики и средства альтернативной медицины:
- Леворин. Курс интенсивной терапии составляет 10 -14 дней, принимать полиеновый антибиотик требуется перорально по 1 таблетке по 5- 6 раз за сутки после приема пищи.
- Нистатин. Что лечить кандидоз полости рта, требуется принимать по 1 таблетке трижды за сутки на протяжении 7 – 14 дней. При повышенной чувствительности к нистатину лучше подобрать аналог.
Лечение candida albicans у женщин
Чтобы восстановить оболочку влагалища, пораженную грибом Кандида, требуется использовать противогрибковые препараты внутрь и наружно. Выбор медикаментов осуществляет лечащий врач в индивидуальном порядке. Для санации влагалища и обработки всех скрытых складок требуется задействовать местные антисептики, в осложненных клинических картинах – системные антибиотики. Народное лечение тоже отличается высокой эффективностью, но только в составе комплексной терапии.
Такие противогрибковые средства предназначены для приема внутрь, а активные компоненты проникают в системный кровоток, истребляют патогенную флору изнутри. Лечить кандидоз такими медикаментами можно только по рекомендации лечащего врача, поскольку имеются медицинские противопоказаний.
- Флюкостат. Необходимо единоразово выпить таблетку 150 мг, после чего выраженные симптомы кандидоза сходят на нет.
- Флуконазол. Это полный аналог вышеописанного медикамента, который тоже предстоит принять единоразово.
Лечить кандидоз требуется не только таблетками перорально, но и кремами, мазями, гелями для использования наружно. Рекомендованный курс интенсивной терапии составляет 2 недели, затем сделать перерыв.
- Пимафуцин. Лечебный состав предстоит задействовать вагинально – утром и вечером в течение 2 – 3 недель.
- Натамицин. Противогрибковую мазь требуется использовать вагинально трижды за сутки на протяжении 2 недель.
Лечить кандидоз суппозиториями эффективней, чем задействовать мази в интенсивной терапии. Действуют вагинальные таблетки локально, истребляют патогенную флору, восстанавливают пораженные ткани слизистой оболочки.
- Полижинакс. Рекомендуется вводить во влагалище по 1 таблетке на ночь, продолжать терапию 10 – 15 дней.
- Тержинан. Таблетки необходимо вводить во влагалище при помощи специального аппликатора. Процедуру проводить на ночь, после не вставать до утра. Курс – 10 – 14 дней.
Чтобы быстрее вылечить кандидоз, больному мужчине и женщине необходимо полностью отказаться в суточном рационе от жирной, жареной, копченой, острой и соленой пищи. Такие вредные блюда только раздражают воспаленные слизистые оболочки, способствуют размножению патогенной флоры. Запрещенные пищевые ингредиенты представлены ниже:
- хлебобулочные изделия;
- сладости, кондитерские изделия;
- сухофрукты;
- соления, копчености;
- свежее молоко.
Разрешенные продукты питания при прогрессирующем кандидозе таковы:
- нежирные сорта мяса и рыбы;
- свежие овощи и фрукты;
- гречневая крупа;
- яйца и обезжиренные сорта твердого сыра;
- зелень.
Кандидоз при беременности
Поскольку при вынашивании плода иммунитет женщины существенно ослаблен, терапия кандидоза в обязательном порядке включает интенсивную витаминотерапию. От приема противогрибковых препаратов перорально требуется полностью отказаться, а использовать представителей данной фармакологической группы преимущественно в форме вагинальных суппозиториев, мазей, кремов и гелей. Кроме того, врачами не запрещено спринцевание отварами ромашки и календулы, использование щелочного раствора (задействовать пищевую соду), сидячие ванночки из целебных трав.
Лечение народными средствами
Методы альтернативной медицины помогают успешно лечить кандидоз при беременности, однако являются надежными терапевтическими мерами и для других категорий пациентов. При отсутствии аллергической реакции на растительные компоненты вот проверенные временем рецепты, чем лечить кандидоз:
- Необходимо приготовить в домашней обстановке или купить в аптеке облепиховое масло, которое с помощью ватного тампона положено наносить на пораженные участки слизистой оболочки трижды в сутки.
- Рекомендуется приготовить классическим методом отвар шалфея, календулы, дубовой коры, крапивы, ромашки. К тому же, можно воспользоваться разбавленным соком алоэ и его целебными свойствами.
Читайте также: